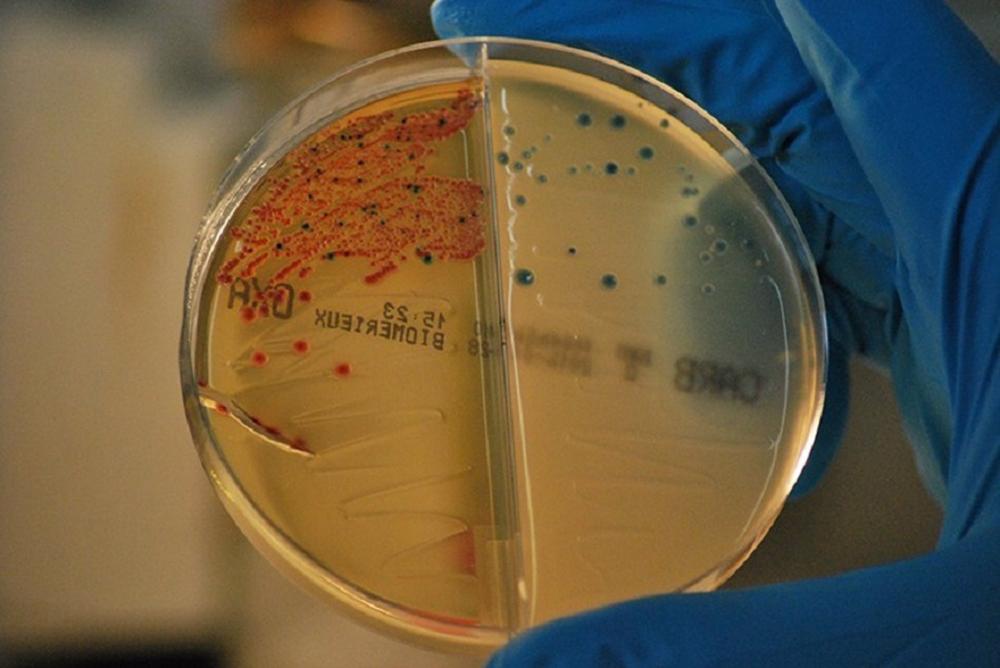
Archivo

Expertos participantes en el Comité de Innovación del Instituto para el Desarrollo e Integración de la Sanidad (Fundación IDIS), en el que han formado parte profesionales de la compañía Pfizer, han resaltado que ’’es crítico’’ priorizar la investigación de nuevos antibióticos para ’’poder tener fármacos eficaces y basados en otros mecanismos de acción lo antes posible’’.
España cuenta con un Plan Nacional para luchar frente Resistencias a Antibióticos que realiza una vigilancia y control del consumo y de la resistencia a los antibióticos, alternativas de prevención y tratamiento, investigación para mejorar el conocimiento sobre la resistencia, formación de los profesionales o concienciación de la población general, entre otros aspectos. Desde el año 2010 se están haciendo grandes esfuerzos en la investigación y desarrollo de nuevos antimicrobianos.
Los medicamentos antimicrobianos, generalmente los antibióticos, que actúan contra las bacterias, son algunos de los recursos más utilizados por los profesionales de la medicina. Sin embargo, en los últimos años se está observando una pérdida de eficacia debida a que los microorganismos mutan o muestran resistencia a los efectos de los antibióticos.
De hecho, si no se toman medidas se estima que en el año 2050 las resistencias a los antimicrobianos (AMR) podrían convertirse en una causa de muerte más común que el cáncer, siendo responsables de 10 millones de muertes en el mundo.
Durante la sesión, en la que han participado la responsable de Relaciones Institucionales con la Sanidad Privada en Pfizer, Alberto López,; el director de la Unidad de Hospitales de Pfizer España, Mario Levada; y el director Médico de Medicina Interna y Hospitales de Pfizer España, Francisco Mesa, se ha explicado que es necesario abordar con urgencia los problemas relacionados con la salud desde un planteamiento global que incluya la salud humana, la animal y la de los ecosistemas, así como las interacciones entre ellas, ya que estamos en un mundo en permanente conexión.
En este sentido, los expertos han propuesto que exista colaboración entre profesionales de distintas disciplinas para poner en marcha medidas de prevención y control de infecciones, concienciación sobre el uso de los antibióticos o definición de cuáles son las prioridades a nivel de investigación.
’’Pfizer es una compañía que lleva investigando en enfermedades infecciosas durante más de 170 años, con nuestro primer antiinfeccioso que data de 1849’’, ha detallado Levada.
’’Estamos orgullosos de ser reconocidos por instituciones independientes como el líder mundial en la lucha contra la RAM desde varias perspectivas: investigación, vigilancia epidemiológica, prevención de infecciones, fabricación responsable y nuestra contribución al debate de políticas en torno a incentivos de I+D sólidos, sostenibles y predecibles. En la actualidad, Pfizer es una de las pocas grandes compañías biomédicas que sigue activa en investigación y desarrollo (I+D) de antiinfecciosos y estamos orgullosos de haber puesto a disposición de los pacientes y profesionales sanitarios una de las carteras de antiinfecciosos más grandes y diversas de la industria. En Pfizer nos tomamos muy en serio la RAM y por ello seguimos investigando en esta área a pesar de los muchos desafíos que existen’’, ha añadido Mesa.
Al finalizar la sesión ha tenido lugar un coloquio con todos los asistentes, en el que ha quedado patente que el manejo de las resistencias antimicrobianas es ya una prioridad en el sector sanitario privado, que tiene en marcha múltiples iniciativas implementándose en este sentido, y el compromiso y ofrecimiento de Pfizer es acompañar a las entidades de la sanidad privada en este reto común.
El secretario general de la Fundación IDIS, Ángel de Benito, ha destacado ’’la importancia de concienciar sobre la prevención de las resistencias antimicrobianas a todos los niveles (desde la administración y profesionales hasta la población general) teniendo en cuenta la problemática de salud pública a la que nos enfrentamos’’.
’’En este sentido, es esencial contar con compañías que sigan investigando con el objetivo de mejorar los resultados en los pacientes y garantizando tratamientos coste-eficaces (que minimicen los efectos adversos asociados a la utilización de antimicrobianos)’’, ha añadido.
Fuente: (EUROPA PRESS)






